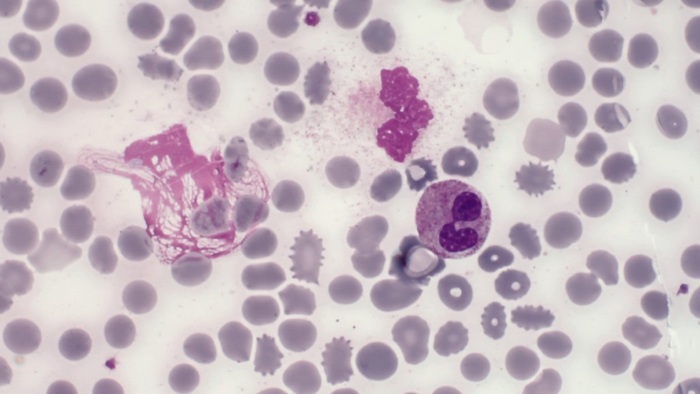
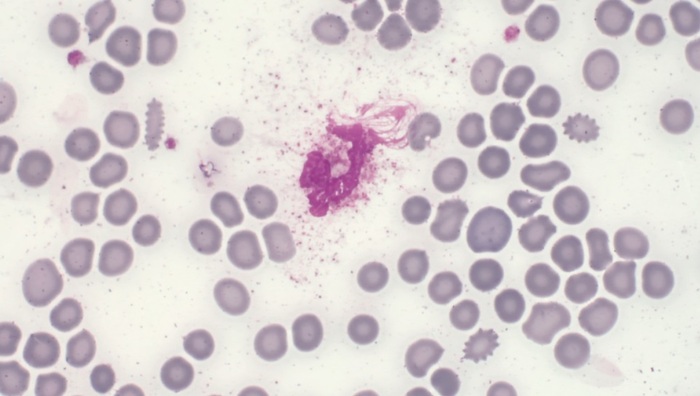
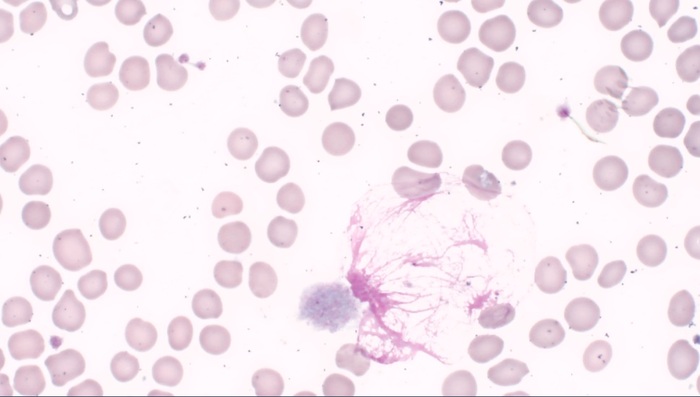
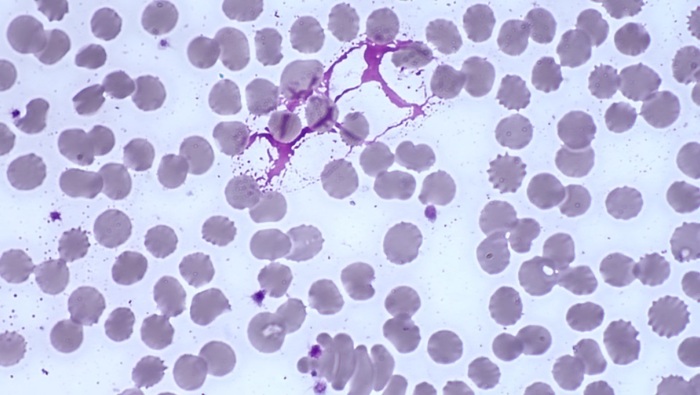
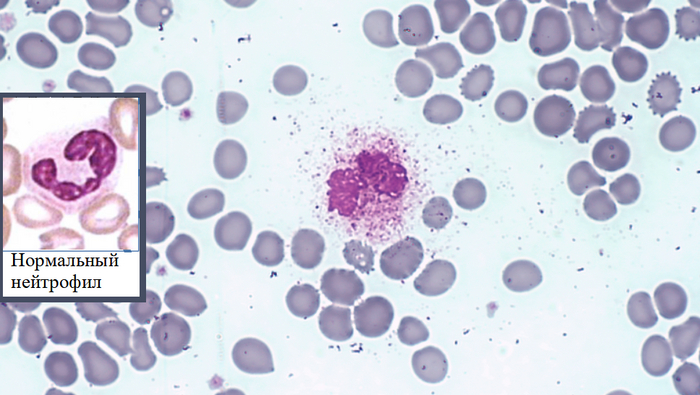
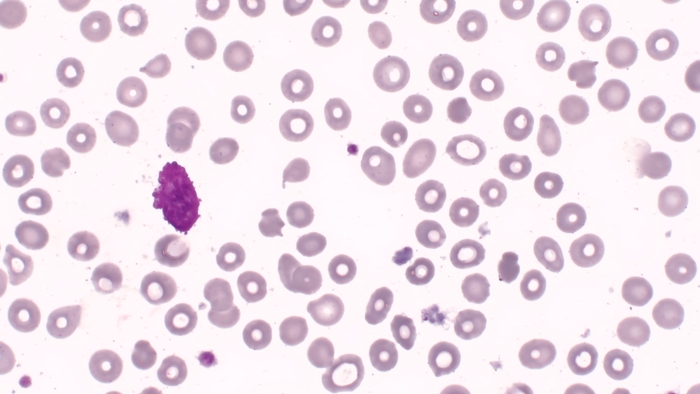

Мне кажется, что фото клеток под микроскопом - это красиво. А фото погибающих клеток - отдельный вид искусства.
Клетка может погибнуть принципиально двумя путями:
1) Молча и спокойно (апоптоз),
2) Наводя панику вокруг (некроз).
Внутри этих пунктов еще есть деление на подгруппы, но не суть.
Гибель вторым путем можно сравнить с гибелью Боромира, который трубил в рог Гондора, чтобы созвать всех на помощь. Он был обречен на гибель (это же Шон Бин), но он хотя бы позвал всех, кого мог, на борьбу с врагом.
Взглянем на нормальные клетки крови. Эритроциты - красненькие, безъядерные, переносят кислород. Лейкоциты выполняют всякие иммунные функции. У них при окраске фиолетовое ядро и голубая или розовая цитоплазма. Розовые, красные, фиолетовые точечки поверх цитоплазмы у некоторых лейкоцитов - это гранулы со всякими биологически активными веществами (поэтому и выделяют отдельно гранулоциты).
При апоптозе (типе клеточной гибели без истерик) клеточная мембрана не нарушается, клеточное ядро сначала будет поделено на фрагменты, потом переварено своими же внутриклеточными ферментами и как-то там утилизировано, а потом утилизируется и цитоплазма.
Ниже представлена пара фотографий апоптоза нейтрофилов.
Теперь о некрозе (это когда клетке суету навести охота). В некрозе нет ничего страшного. Это нормальная реакция организма при воспалении, например. Проникла бактерия - нейтрофилы героически гибнут, испуская из своего тела коктейль (цитокиновый коктейль - научный термин) из химических веществ, имеющих много свойств, в том числе предназначенных привлекать в очаг воспаления более мощную артиллерию - какие-то типы остальных лейкоцитов. Нейтрофилы, как условные пограничники, в том числе сигнализируют о нападении на организм в определенном месте, а другие лейкоциты придут, уже как подразделения нормальной армии.
Беда случается, когда некроза слишком много. Если клетки гибнут слишком стремительно, слишком массово, так и организму умереть можно... При некрозе клеток в окружающую среду попадает мощный коктейль из химических веществ, и если некроза будет слишком много, то всё обернется коктейлем Молотова против нас самих. Это называют цитокиновым штормом.
Взглянем на фото некроза нейтрофила. Клеточная мембрана разрушена - содержимое клетки разбросано равномерно вокруг, ядро клетки уже некоторое время растекается. Содержимое ядра в окружающей среде - это буквально таки ядрёнейший химический коктейль.
Взглянем на групповое фото нейтрофилов ниже. Надутые как шарики нейтрофилы, в которых много воды, поэтому и ядро, и гранулы оттеснены к периферии клетки. Может эти клетки лопнут? И тогда мы увидим то, что видели на предыдущем фото.
Кстати, обратите внимание, как меняются эритроциты по периферии от этих нейтрофилов - обрастают совершенно лишними вакуолями.
Вспоминается классическое "В общем, он лопнул!" Хотя на самом деле не было там такого эпического хлопка. Содержимое просто вытекло и всё.
А вот фото лопнувшего нейтрофила и растекающегося лимфоцита. Обратите внимание, как красиво растекается в разные стороны лимфоцит - голубая цитоплазма в одну сторону, фиолетовое ядро в другую...
Еще одно фото нейтрофилов:
Иногда содержимое ядра с цитоплазмой так перемешивается, что становится вообще однородной субстанцией:
Представлены фотографии мазков крови больных, умерших от ковида. Увеличение объектива х100, фото сделано с использованием капли масла между объективом и предметным стеклом (с иммерсией, если по-научному). Окраска по Романовскому-Гимзе.